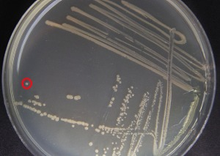
single_colony.jpg__220x156_q85_crop_subsampling-2_upscale.png

Aug 22, 2020
Streaking and Isolating Bacteria on an LB Agar Plate - CHEM 584

- Addgene The Nonprofit Plasmid Repository1,
- Ken Christensen2
- 1Addgene;
- 2Brigham Young University

External link: https://www.addgene.org/protocols/streak-plate/
Protocol Citation: Addgene The Nonprofit Plasmid Repository, Ken Christensen 2020. Streaking and Isolating Bacteria on an LB Agar Plate - CHEM 584. protocols.io https://dx.doi.org/10.17504/protocols.io.bj5mkq46
License: This is an open access protocol distributed under the terms of the Creative Commons Attribution License, which permits unrestricted use, distribution, and reproduction in any medium, provided the original author and source are credited
Protocol status: In development
We are still developing and optimizing this protocol
Created: August 22, 2020
Last Modified: August 22, 2020
Protocol Integer ID: 40845
Keywords: isolating bacteria on an lb agar plate, bacteria on an lb agar plate, isolating bacteria, lb agar plate, bacteria, streaking, chem
Abstract
This protocol describes how to streak and isolate (single colony) bacteria on an LB agar plate. To see the full abstract and additional resources, please visit https://www.addgene.org/protocols/streak-plate/.
Sample Data
Figure 1: Streaked out plate with single colony (red circle).
Guidelines
Streaking diagram and guide for spreading bacteria

Diagram: streaking motions on a plate for achieving single colonies
Streak #1. Using a sterile loop, pipette, or toothpick, touch the bacteria growing wihin the punctured area of the stab culture or the top of the glycerol stock and gently spread the bacteria over a section of the plate in a zig-zag motion, as shown in the diagram above.
Streak #2. Using a fresh, sterile toothpick or freshly sterilized loop, gently drag through streak #1 and spread the bacteria in a zig-zag motion over a second section of the plate.
Streak #3. Using a third sterile pipette tip, toothpick, or sterilized loop, gently drag through streak #2 and spread the bacteria over the last section of the plate.
Materials
Reagents
- Sterile toothpicks or wire loop
- Bunsen burner (or other small flame source)
- Incubator
- Marker
Reagents
- LB agar plate (with appropriate antibiotic)
- Bacterial stab
Troubleshooting
Day 1
Obtain an LB agar plate with appropriate antibiotic.
Label the bottom of the plate with the plasmid name and the date. It is also a good idea to add the antibiotic resistance and your initials. Labeling within a laboratory setting is important for organization, and it is recommended that you keep a standard labeling system for all your objects/solutions.
Sterilize your lab bench by spraying it down with an appropriate disinfectant and wiping it down with a paper towel. Maintain sterility by working near a flame or bunsen burner.
Obtain the approrpriate bacterial stab, overgrown plate, or glycerol stock.
Using a sterile loop, pipette tip or toothpick, touch the bacteria growing within the punctured area of the stab culture or the top of the glycerol stock.
Note
*Pro-Tip*
If you use a wire loop you can sterilize it by passing it through a flame, just be sure to allow enough time for the loop to cool before touching it to the bacteria.
Gently spread the bacteria over a section of the plate, as shown in the diagram (see Guidelines & Description), to create streak #1.
Note
*Pro-Tips*
- Hold your toothpick at an angle, the way you would hold a pencil so that you can make a broad stroke. Only touch the surface of the plate, do NOT dig into the agar.
- Another very popular technique is to draw in discontinuous lines. Start by streaking a vertical line of bacteria along one edge of the plate. Then streak horizontal lines in another section of the plate, and then diagonal lines in another section of the plate. Make sure that the first line (and only the first) in each new section crosses at least one line of the previous section so that it will contain some bacteria.
Using a fresh, sterile toothpick, or freshly sterilized loop, gently drag through streak #1 and spread the bacteria over a second section of the plate, to create streak #2.
Using a third sterile pipette tip, toothpick, or sterilized loop, gently drag through streak #2 and spread the bacteria over the last section of the plate, to create streak #3.
Incubate plate with newly plated bacteria overnight (12:00:00 -18:00:00 ) at 37 °C .
Note
*Pro-Tip*
Some plasmids or bacteria need to be grown at 30 °C instead of 37 °C . This is often true for large unstable plasmids, which sometimes recombine at 37 °C . Be sure to check this before incubating your plate.
Day 2
In the morning, single colonies should be visible. A single colony should look like a white dot growing on the solid medium. This dot is composed of millions of genetically identical bacteria that arose from a single bacterium. If the bacterial growth is too dense and you do not see single colonies, re-streak onto a new agar plate to obtain single colonies.
Once you have single colonies, you can proceed to recovering plasmid DNA or use the indivdual colonies for other experiments.
